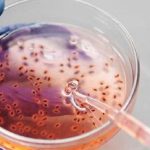

La sede palermitana del Tribunale amministrativo regionale si è così espressa sul ricorso di un candidato escluso dalla prova scritta, obbligando l’ente organizzatore a predisporre una sessione straordinaria.
I candidati che non si sono potuti presentare a un esame perché malati di Covid-19 hanno diritto a una prova supplementare, anche se non espressamente prevista dal bando. La violazione di questo principio determina l’annullamento del concorso. Come sottolineato dal sindacato Nursind, è questa l’indicazione dettata dalla sentenza n. 1427/2022 della seconda sezione del Tar Sicilia, sede di Palermo, sul ricorso di un candidato affetto da Covid ed escluso dalla prova scritta.
Il Tribunale amministrativo regionale ha accolto il ricorso, obbligando l’ente organizzatore (Comune di Castelbuono) a predisporre una sessione straordinaria del concorso (copertura a tempo pieno ed indeterminato di un posto di istruttore tecnico – cat. C) per consentire all’assente di parteciparvi. Secondo i giudici, la vicenda si inserisce nel particolare momento storico che, al fine di limitare la diffusione di infezioni da Covid, ha previsto l’obbligo dell’isolamento domiciliare a soggetti colpiti dal virus, seppur con sintomi assenti o lievi. Per far fronte a tale situazione il legislatore ha adottato una serie di misure volte a contemperare l’esigenza di svolgere comunque i procedimenti concorsuali indetti, quella di garantire idonei standard di sicurezza sanitaria, nonché quella di non pregiudicare l’interesse della maggiore partecipazione possibile alle procedure concorsuali.
In tal senso si muovono le previsioni contenute all’art. 10 del Decreto legge n. 44 del 2021, convertito in Legge n. 76/2021, che prevedono misure varie (in parte derogatorie alle ordinarie procedure), volte a rendere possibile lo svolgimento dei concorsi pubblici durante il periodo di emergenza sanitaria. Tra queste misure, sostiene il Tar, appare significativa quella che consente lo svolgimento delle prove di concorso in modo non contestuale tra tutti i candidati.
In applicazione dei principi di ragionevolezza e proporzionalità il Collegio ha stabilito che non vi è alcuna valida ragione per ritenere preclusa la possibilità di indire una sessione straordinaria al fine di consentire lo svolgimento delle prove concorsuali al ricorrente che, alla data di svolgimento ordinario delle prove, si trovava in isolamento domiciliare. Possibilità da garantire anche in mancanza di espressa previsione nel bando.
Non si tratta, tuttavia, di un orientamento consolidato. Basti ricordare la pronuncia n. 152/2022 della prima sezione del Tar Puglia, sede di Bari, che ha escluso la possibilità di una prova straordinaria e riservata se non prevista dal bando. La posizione dei giudici siciliani è invece sostenuta dalla pronuncia n. 463/2022 del Tar Roma, sezione 3-bis, e da quelle n. 5666/2021 del Consiglio di Stato, sezione VI, e n. 5666/2021 del Tar Roma, sezione 3.
Redazione Nurse Times
- Dalla prevenzione personalizzata e precoce alle nuove terapie: esperti a confronto sul futuro della lotta a infarto, ictus e trombosi
- Diabete di tipo 1, si lavora allo sviluppo di un nuovo pancreas artificiale: l’IA gestisce la glicemia senza aspettare i sintomi
- Anoressia nervosa e assistenza infermieristica: prospettive cliniche e multidisciplinari
- Asl BAT, Fials detta le priorità alla nuova Direzione: “Subito diritto alla mensa, assunzioni oss e produttività”
- Martina Franca, infermieri usati come oss in Cardiologia e UTIC. Nursind scrive all’Asl Taranto: “Sicurezza delle cure a rischio”

Lascia un commento